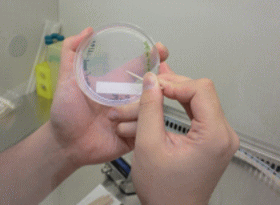

◆◇◆ ━━━━━━━━━━━━━━━━━━━━━━━━━━━ ◆◇◆
NBRCニュース No. 23(2013.10.1)
◆◇◆ ━━━━━━━━━━━━━━━━━━━━━━━━━━━ ◆◇◆
NBRCニュース第23号をお届けします。今号は微生物あれこれ、微生物の保存
法、特許微生物寄託のイロハ、NITEが解析した微生物ゲノムの4つの連載をお
届けします。最後までお読みいただければ幸いです。
(等幅フォントでご覧ください)
======================================================================
内容
======================================================================
1.新たにご利用可能となった微生物株(2013年7月23日~9月17日)
2.微生物あれこれ(20)
微細藻類の収集(1)
3.微生物の保存法(12)
継代数の数え方とシードロットシステム
4.特許微生物寄託のイロハ (4)
生存確認試験ではなにしているの?
5.NITEが解析した微生物ゲノム (11)
カルバゾール分解菌Pseudomonas resinovorans NBRC 106553 (= CA10)
6.NITEバイオテクノロジーセンター展示のお知らせ
======================================================================
1.新たにご利用可能となった微生物株(2013年7月23日~9月17日)
======================================================================
糸状菌18株、バクテリア40株、微生物ゲノムDNA 2種類を新たに公開しまし
た。
【新規公開株一覧】 新たに分譲を開始した微生物資源
======================================================================
2.微生物あれこれ(20)
微細藻類の採集(1) (岡田和也)
======================================================================
現在NBRCで公開している微細藻類は318株あり、これらには皆様から寄託さ
れた株や海洋バイオテクノロジー研究所(MBI)から譲渡された株に加え、
NBRC独自に採集している株があります。今回は、微細藻類を対象にした採集活
動(サンプリング)について、私が習得した経験をもとに、基礎編として概要
を紹介したいと思います。
◆微細藻類の採集手順
(1) 事前準備
採集に使用する培地を準備します。NBRCでは淡水域ではAF6(NBRC medium
No. 964)を、海水域ではIMK(SW)(NBRC medium No. 963)をよく使用し
ています。
(2) サンプリング
微細藻類が生息していそうな日当たりのよい場所からサンプルを採取し、実
験室に持ち帰ります。
(3) サンプルの予備培養および単離(純化)作業
持ち帰ったサンプルを各種培地で培養し、増殖した微細藻類の純化を行いま
す。
(4) 単離株の同定
純化した株は、形態観察やリボゾーム小サブユニット配列(16S・18S)など
の情報を基に同定を行います。
(5) NBRC登録株の選抜(新規性の有無、特性評価)
同定した株は、株の特性を調べ、新規性が認められたものや産業有用性が期
待される株を中心にNBRC株として登録し、公開しています。
以上が簡単な採集手順となりますが、そのほか経験を通じて感じた留意する
点などを、ご紹介させていただきたいと思います。
◆サンプリング場所での経験
多くの微生物同様、微細藻類のほとんどは肉眼で確認することが不可能なた
め、フィールドで特定の微細藻類を選んで採集することはできません。そのた
め、初めてのサンプリングでは多種多様なサンプルを採取しました。実験室で
これらのサンプルを観察してみると、海や山、温泉といった自然環境だけでな
く、工場の排気ガス噴出口や、ガードレールやコンクリートの表面からでも、
微細藻類を確認することができました。生息域の広さに驚かされると同時に、
求める微細藻類を高確率で取得するためには、多様なサンプルを採取すること
の重要性を実感しました。多くのサンプルを採集するには、効率を考える必要
があるため、私たちは、個別包装されたウェットタイプの綿棒を使用し、サン
プルを採取した綿棒をその場で液体培地に入れて実験室に持ち帰っています。
またGPS機能付きのデジタルカメラを使用して、採取場所、状態、採取方法な
どの情報の記録を簡略化しています。サンプルを実験室に持ち帰るまでの温度
管理は重要で、私たちは移動中の極端な温度変化を避けるために、温冷庫を持
参し、フィールドの温度に合わせた状態で、持ち帰っています

サンプルの採取
◆実験室での経験 実験室に戻ると、1つのサンプルに対して数種の培地や培養条件で培養を行 うために、観察が必要なサンプルが増大します。初めてフィールドに出てサン プリングをした際には、実験室での作業量を考慮していなかったため、実験室 で四苦八苦しました。現在、私はコロニーピックアップ法で純化作業を行って おりますが、微細藻類はカビやバクテリアよりも増殖スピードが遅いために、 寒天平板培地の確認を少しでも怠ると、他の微生物が培地全体に増殖してしま います。そのため、数日ごとに全てのサンプルを確認して、根気良くピックア ップを繰り返し、カビやバクテリアなどが共存していないコロニーを得る必要 がありました。
コロニーピックアップ法
◆最後に 私が初めて単離した株は、山の中のガードレールから単離したクロレラ (Chlorella)で、非常に愛着があります。現在のところ、この株の有用性は 不明ですが、今後自分が単離した株を有用微生物として皆様に使用していただ けることを目標に日々「藻」がきながら、業務を行っています。 【AF6とIMK(SW)の組成】培地一覧 ====================================================================== 3.微生物の保存法(12) 継代数の数え方とシードロットシステム (中川恭好) ====================================================================== 薬局方の培地性能試験や適合性試験では、試験菌株を継代回数が5回以内の うちに使用することが求められています。また、NBRCから受け取ったアンプル は何世代目かというご質問もよくいただいておりますので、今回は継代数の数 え方と継代数を増やさない管理方法をご紹介いたします。
◆継代数の数え方 薬局方等で管理する菌株の世代数は、保存機関から 入手した菌株を復元して得られた培養物を1世代目と します(「第十五改正日本薬局方第一追補の制定に伴 う試験法等に関する質疑応答集(Q&A)について」、 厚生労働省医薬食品局審査管理課事務連絡、平成21年 9月29日)。そして新しい培地に植え替えるごとに1世 代ずつ増やして数えます(図1)。管理簿を作成して 継代回数を管理することも重要です。 ◆シードロットシステム 微生物は、培養を繰り返すうちに胞子形成能や色素 産生能の低下や喪失などの性質の変化がおきることが 知られています。また植え替えにはコンタミネーショ ンの恐れがあるため、植え替えの回数を増やせばコン タミネーションの可能性も増えます。そのため、菌株 を入手したらできるだけ早い時点で保存することが重 要です。また、前述したように培地性能試験などでは、 |
 図1.世代数の数え方 |
試験菌株の継代回数が5回以内のうちに菌株を使用することが求められていま す。微生物の継代数を増やさないためには、シードロットシステムの利用をお 勧めします(図2)。保存機関から入手した標品を復元・培養して得られた1代 目を大量培養した2代目から凍結などの保存標品を複数作製して、これをシー ド標品とします。そして実験にはこの保存標品を復元した3代目を用います。 シード標品が10本あれば、少なくとも10回は継代数を増やすことなく実験を行 うことができます。継代数を増やさないためには、保存する標品の数が多けれ ば多いほど良いことは間違いありませんが、実用的には保管スペースやコスト にあわせて決めればよいでしょう。薬局方指定株の凍結保存法については、 「一般的な細菌の凍結保存法」(NBRCニュース創刊号)、「一般的な糸状菌の 凍結保存法」(第3号)、「酵母の凍結保存法」(第7号)に掲載しております ので、バックナンバーをご参考ください。

図2.シードロットシステム
【厚生労働省法令等データベースサービス】 https://www.mhlw.go.jp/hourei/ (※URLの変更がありましたので修正しました。2019年12月16日) 「第十五改正日本薬局方第一追補の制定に伴う試験法等に関する質疑応答集 (Q&A)について」は、「通知検索」から検索してご覧ください。 ====================================================================== 4.特許微生物寄託のイロハ (4) 生存確認試験ではなにしているの? (佐藤真則) ====================================================================== 今回は特許寄託微生物の生存確認試験についてご紹介します。生存確認試験 の実施は、経済産業省が定めた特許微生物寄託等事業実施要綱及びブダペスト 条約により義務づけられており、寄託申請書に記載された培養条件(培地、温 度、日数等)に従って、(1) 寄託が行われたとき、(2) その微生物の保存上必 要と認められるとき、(3) 寄託者の請求があったとき、に行われます。試験方 法は寄託微生物種によって異なりますが、ここではおおまかに3つに分けてそ の方法をご説明します。 ◆微生物の生存確認試験 標品1本を使用し、10倍希釈系列の液体培地での培養ならびに平板培養を行 います。これらを指定期間培養して、液体培地の濁度やコロニー形成の有無か ら増殖の有無を確認し、生菌数をプレートのコロニー数からcolony forming unit(c.f.u.)として求めます。さらにコロニー形態の観察及び光学顕微鏡観 察と記録を行います。これと同時に汚染検査も行い、画線培養したプレートに 出現するコロニーが単一種かどうかを顕微鏡観察で検査します。2種以上のコ ロニーが確認された場合、まずNITE特許センターで汚染かコロニーバリエーシ ョンかについて判断します。しかし、判断に迷う場合には寄託者に確認してい ただき、汚染か否かを決めています。 試験平均日数:細菌3日、酵母5日、糸状菌・放線菌7日 ◆動物細胞の生存確認試験 標品1本を使用して、トリパンブルー排除法による生存率の測定と寄託申請 書に記載された培養条件での継代培養による増殖能の確認を行います。トリパ ンブルー排除法では、凍結標品を37℃で急速解凍し、細胞を遠心洗浄します。 これを新鮮な培地に懸濁し、その一部と0.4%トリパンブルーを1:1の割合で混 合します。色素を透過する細胞を死細胞とし、透過しない細胞を生細胞として その比率を計算することで生存率を測定します。その後は継代培養を行い、細 胞の正常な増殖を確認します。この間に、顕微鏡観察により一般的な細菌、カ ビ、酵母の汚染検査を行います。次に顕微鏡観察では判断できないマイコプラ ズマについて、DNA間接蛍光法及びPCR法によって汚染検査を行います。DNA間 接蛍光法では、継代培養液をVero細胞を培養したチャンバーに添加して、この 細胞を4~5日間培養した後、Vero細胞をスライドガラスに固定し、DNAを蛍光 染色します。マイコプラズマが汚染している場合には、細胞の表面にたくさん のマイコプラズマ由来のDNAの蛍光が観察されます。またPCR法では、マイコプ ラズマに特異的なプライマーを使って遺伝子を増幅することで判断します。 試験平均日数:動物細胞3~4週間

トリパンブルー排除法 DNA間接蛍光法
◆その他の生存試験 バクテリオファージは、宿主を培養したプレート上にファージを添加して、 そのプラーク数を測定します。受精卵は、標品を急速融解して洗浄した後、細 胞を観察して形態が正常であるかどうかで判断します。継代で維持している植 物細胞、原生動物、微細藻類は、寄託申請書に書かれた指定培養条件で正常に 増殖するかを調べるとともに、指定培地とそれ以外の培地で汚染検査を行いま す。プラスミドは、電気泳動にてバンドを確認します。種子は発芽率を検査し ます。 試験平均日数:バクテリオファージ・受精卵7日、植物細胞・原生動物・ 微細藻類2~4週間、プラスミド1日、種子3~4週間 不明な点や質問等ございましたら、NITE特許センター宛に遠慮無くご連絡く ださい(0438-20-5580)。次回は「よくある質問」についてご紹介します。 ====================================================================== 5.NITEが解析した微生物ゲノム (11) カルバゾール分解菌Pseudomonas resinovorans NBRC 106553 (= CA10) (山副敦司) ====================================================================== Pseudomonas resinovorans NBRC 106553 (= CA10)は、東京大学・大森俊雄 名誉教授らのグループにより我が国の活性汚泥から単離された菌株で、発がん 性が疑われる難分解性化合物のカルバゾールを唯一の炭素源・窒素源・エネル ギー源として生育可能な細菌です。その後、東京大学生物生産工学研究センタ ー環境保全工学研究室・野尻秀昭教授に引き継がれ、2010年にNBRCに寄託され ました。本菌株は、カルバゾール以外にもフルオランテン等の多環芳香族化合 物や低塩素化ダイオキシン等、人に対し毒性が疑われる物質に対しても分解能 を有することが明らかになってきたことから、本菌株を用いたバイオレメディ エーション(環境浄化)や物質変換による有用物質生産への応用が期待されて います。 NBRCでは、第2世代シーケンサー(Roche 454およびIllumina HiSeq1000)な らびにABI 3730を用いたサンガー法との組み合わせにより、P. resinovorans NBRC 106553の全ゲノムを解析しました。P. resinovorans NBRC 106553は、約 6.3 Mbの環状染色体と約200 kbの環状プラスミドを保有することが明らかにな り、アノテーションの結果から染色体上には5738個、プラスミド上には223個 の遺伝子が予測されました。このうち、カルバゾールからカテコールまでの分 解に関与する遺伝子群はプラスミド上に、カテコールの代謝に係わる分解遺伝 子群は染色体上に確認されました。また、これらの他にも、フェノールやPCB 等の芳香族化合物の代謝に関与すると考えられる約240個の遺伝子が見つかり ました。これらの遺伝子はゲノム解析が終了している他の12株のPseudomonas 属では約50個から180個しか存在しないため、P. resinovorans NBRC 106553が 多様な芳香族化合物の代謝能を有している可能性が示唆されます。
Shintani M. et al. (2013). Complete genome sequence of the carbazole degrader Pseudomonas resinovorans strain CA10 (NBRC 106553). Genome Announc. Jul 25;1(4). https://mra.asm.org/content/1/4/e00488-13.full ====================================================================== 6.NITEバイオテクノロジーセンター展示のお知らせ ====================================================================== 以下に出展いたします。お立ち寄りいただいた皆様からのご相談やご質問に もお答えします。是非お越しください。 BioJapan 2013 日程:2013年10月9日(水)~11日(金) 場所:パシフィコ横浜(横浜市西区みなとみらい1-1-1) NBRCブースセミナー: 9日 13:30-13:45 おいしい糸状菌たち 15:30-15:45 新・微生物バックアップ 10日 11:00-11:15 名古屋議定書と微生物バックアップ 13:30-13:45 アジアの微生物合同探索について 15:30-15:45 名古屋議定書と微生物バックアップ 11日 11:00-11:15 放線菌を用いた新規化合物創出の可能性について 13:30-13:45 バイオエタノールと微生物 第29回日本微生物生態学会大会 日程:2013年11月23日(土)~25日(月) 場所:鹿児島大学郡元キャンパス(鹿児島市郡元1-21-24) ====================================================================== 編集後記 ====================================================================== 小学校の理科で植物の発芽に必要な条件は「水・温度・光」と習いました。 これらは、我々動物の1種類である人間が、生活していく上でも必要な要因で もあります。しかし、何事も程々が良いと実感した2013年の夏でした。(HS) ◆◇◆ ━━━━━━━━━━━━━━━━━━━━━━━━━━━ ◆◇◆ ・受信アドレス変更、受信停止は以下のサイトからお手続き下さい。 https://www.nite.go.jp/nbrc/cultures/others/nbrcnews/nbrcnews.html ・NBRCニュースは配信登録いただいたメールアドレスにお送りしております。 万が一間違えて配信されておりましたら、お手数ですが、下記のアドレスに ご連絡ください。 ・ご質問、転載のご要望など、NBRCニュースについてのお問い合わせは、下記 のアドレスにご連絡ください。 ・掲載内容は予告なく変更することがございます。掲載内容を許可なく複製・ 転載されることを禁止します。 ・偶数月の1日(休日の場合はその前後)に配信します。第24号は12月2日に配 信予定です。 編集・発行 独立行政法人製品評価技術基盤機構(NITE)バイオテクノロジーセンター NBRCニュース編集局(nbrcnews@nite.go.jp) ◆◇◆ ━━━━━━━━━━━━━━━━━━━━━━━━━━━ ◆◇◆









